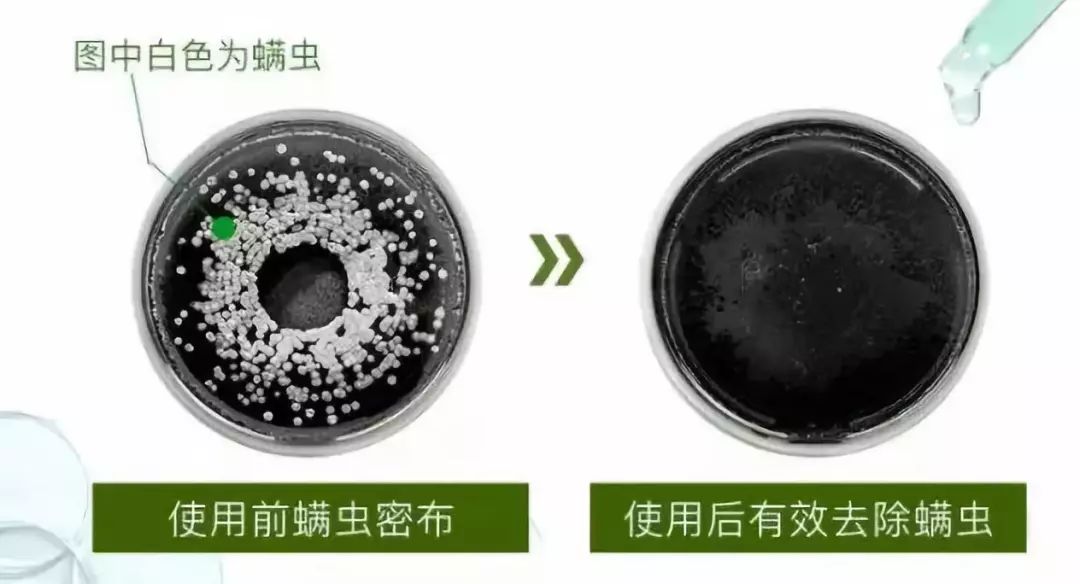
别总想着烫头发!过了30岁,这样弄头发才显年轻

30岁烫什么发型显年轻 30岁女人烫发发型(2)
400x489 - 23KB - JPEG

30岁烫什么发型显年轻 30岁女人烫发发型(3)
400x491 - 27KB - JPEG

30岁烫什么发型显年轻 30岁女人烫发发型
400x503 - 34KB - JPEG
30多岁女人脸大烫什么发型好?10款适合大脸的
384x442 - 23KB - JPEG

30岁烫什么发型显年轻 30岁女人烫发发型_香
400x504 - 23KB - JPEG

30多岁的女人长脸烫什么头发好看 中年长脸女
380x480 - 27KB - JPEG
中年女性过年要烫什么样的头发可以显得年轻呢
900x798 - 181KB - JPEG

留什么发型显年轻洋气
300x200 - 39KB - JPEG
30多岁的女人剪短发适合这三种,剪完瞬间年轻
508x649 - 30KB - JPEG
别总想着烫头发!过了30岁,这样弄头发才显年轻
1080x584 - 59KB - JPEG

2017最新的发型都在这!30+的女人这样烫,至少
600x600 - 32KB - JPEG

2017秋冬最美卷发都在这!30岁女人这样烫,起码
388x474 - 27KB - JPEG

2017秋冬最美卷发都在这!30岁女人这样烫,起码
422x449 - 25KB - JPEG

30岁到40岁留这款发型显年轻,好发型少不了剪
640x427 - 17KB - JPEG

2017最新的发型都在这!30+的女人这样烫,至少
600x600 - 21KB - JPEG